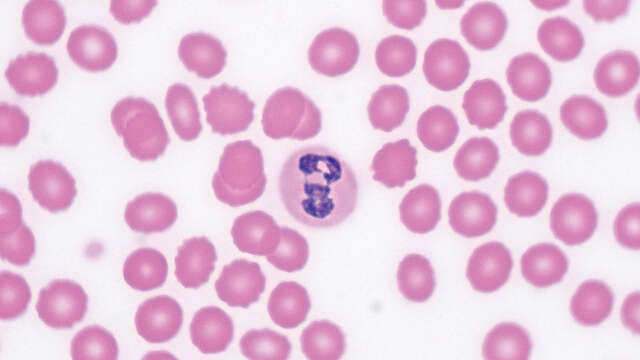

Kính Hiển Vi Soi Vi Khuẩn Tinh Trùng: Giải Pháp Đột Phá Cho Thú Y Và Chăn Nuôi
Trong ngành chăn nuôi hiện đại, việc kiểm soát dịch bệnh và tối ưu hóa hiệu suất sinh sản là hai yếu tố then chốt quyết định lợi nhuận. Kính hiển vi soi vi khuẩn tinh trùng đã trở thành thiết bị không thể thiếu, giúp các chuyên gia thú y đưa ra những quyết định chính xác và kịp thời.
1. Tại sao cần trang bị kính hiển vi trong chăn nuôi?
Việc sở hữu một chiếc kính hiển vi chất lượng cao tại trang trại hoặc phòng khám giúp bạn chủ động hoàn toàn trong:
-
Kiểm tra chất lượng tinh dịch: Đánh giá mật độ, độ di động của tinh trùng trước khi phối giống, giúp tăng tỷ lệ đậu thai.
-
Chẩn đoán bệnh sớm: Phát hiện nhanh các loại vi khuẩn, ký sinh trùng đường máu, ghẻ hoặc nấm da trên vật nuôi.
-
Tiết kiệm chi phí: Giảm thiểu rủi ro phối giống hỏng và hạn chế việc sử dụng kháng sinh vô tội vạ khi chưa rõ nguyên nhân gây bệnh.

2. Đặc điểm nổi bật của kính hiển vi chuyên dụng cho thú y
Khác với các dòng kính học tập thông thường, kính hiển vi dùng trong thú y cần đáp ứng các tiêu chuẩn khắt khe về độ sắc nét và độ bền:
Độ phóng đại tối ưu
Để soi rõ vi khuẩn, kính cần có độ phóng đại lên đến 1000x (với vật kính dầu). Đối với soi tinh trùng heo, bò, gà, độ phóng đại 400x là mức lý tưởng để quan sát hình thái và chuyển động.

Hệ thống chiếu sáng Led lạnh
Ánh sáng LED giúp bảo vệ mẫu vật, đặc biệt là tinh trùng, tránh bị sốc nhiệt hoặc chết trong quá trình quan sát kéo dài.

Khả năng kết nối camera (Tùy chọn)
Các dòng kính hiển vi kỹ thuật số cho phép kết nối với màn hình máy tính hoặc tivi, giúp bạn dễ dàng tư vấn cho khách hàng hoặc lưu trữ hồ sơ bệnh án.

3. Top các dòng Kính Hiển Vi Soi Vi Khuẩn Tinh Trùng được tin dùng nhất hiện nay
| Dòng máy | Mục đích sử dụng | Ưu điểm |
| Dòng 2 mắt tiêu chuẩn | Soi tinh trùng, ký sinh trùng | Hình ảnh trung thực, chống mỏi mắt |
| Dòng có màn hình LCD | Theo dõi tại trang trại | Tiện lợi, không cần máy tính, xem nhóm |
| Dòng kỹ thuật số USB | Lưu trữ hình ảnh, video | Dễ dàng chia sẻ dữ liệu qua Zalo, Facebook |
4. Hướng dẫn chọn mua kính hiển vi phù hợp
Để chọn được thiết bị ưng ý, bạn nên lưu ý 3 tiêu chí sau:
-
Vật kính: Nên chọn vật kính tiêu sắc (Achromatic) để hình ảnh phẳng và không bị nhiễu màu ở rìa.
-
Bàn sa trượt: Phải di chuyển mượt mà để dễ dàng bám đuổi theo chuyển động của tinh trùng.
-
Chế độ bảo hành: Ưu tiên các đơn vị có kỹ thuật viên am hiểu về ngành thú y để được hỗ trợ hướng dẫn sử dụng chuyên sâu.

Lưu ý: Đối với việc soi tinh trùng, việc trang bị thêm bàn gia nhiệt là cực kỳ quan trọng để giữ ấm mẫu vật, đảm bảo kết quả đánh giá chính xác nhất.
5. Mua kính hiển vi thú y ở đâu uy tín?
NIVINA tự hào là đơn vị cung cấp các dòng kính hiển vi chuyên dụng cho ngành chăn nuôi với:
-
Hàng chính hãng, đầy đủ giấy tờ.
-
Hỗ trợ kỹ thuật, hướng dẫn soi mẫu thực tế cho khách hàng bởi kỹ sư được đào tạo chuyên sâu từ hãng NIKON
-
Giá cả cạnh tranh nhất thị trường.
Liên hệ ngay hotline để được tư vấn dòng Kính Hiển Vi Soi Vi Khuẩn Tinh Trùng phù hợp với ngân sách của bạn!
Đại lý chính hãng – Top 5 Kính Hiển Vi Phản Pha Nikon
Suốt nhiều năm liền là đại lý chính hãng NIKON cả mảng Thiết bị Sinh Học lẫn Thiết Bị Công Nghiệp, NIVINA tự hào đem đến giải pháp toàn diện cùng Kỹ sư chuyên môn tay nghề cao, dịch vụ Hiệu Chuẩn Quốc Tế ISO17025:2017 VILAS1336
Zalo OA: 086 986 5068
Fanpage: Ni Vina – Hóa chất và Thiết bị
Email: ms1@nivina.com.vn
Địa chỉ:
Trụ Sở – Hà Nội: Ô DV3-2.10, Tầng 2, Tòa nhà CT2&3, KĐT Dream Town, đường 70, Tây Mỗ, Nam Từ Liêm, Hà Nội
Chi Nhánh Hồ Chí Minh: Tầng 3, Số 77 Tân Kỳ Tân Quý, Phường Tân Sơn Nhì, Quận Tân Phú, TP. HCM